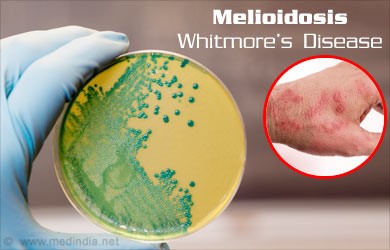

🔔Join APTI PLUS Prelims Mirror 2026 | All India Open Mock Test Series on 12th April, 26th April & 3rd May 2026 |Register Now!
Disclaimer: Copyright infringement not intended.
Context
Melioidosis
https://epaper.thehindu.com/Home/ShareArticle?OrgId=G1H944QLI.1&imageview=0








© 2026 iasgyan. All right reserved